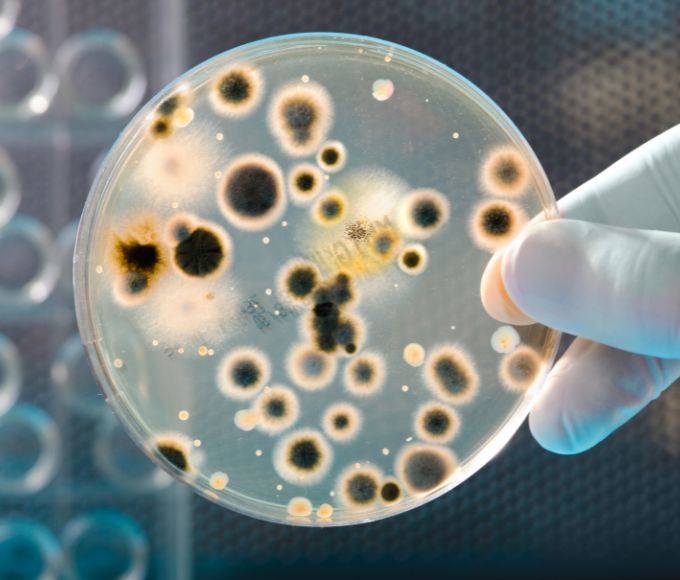
Methylchloroisothiazolinone

Methylchloroisothiazolinone (CMIT): Chất Bảo Quản Phổ Biến Từ Công Nghiệp Đến Mỹ Phẩm
Methylchloroisothiazolinone (CMIT) là một trong những chất bảo quản, chất diệt khuẩn phổ biến và hiệu quả nhất được sử dụng rộng rãi trong nhiều ngành công nghiệp và sản phẩm tiêu dùng trên toàn cầu. Từ các hệ thống xử lý nước quy mô lớn, sản xuất sơn, keo dán công nghiệp cho đến những chai dầu gội, sữa tắm hay nước rửa chén quen thuộc trong mỗi gia đình, CMIT đóng vai trò then chốt trong việc ngăn chặn sự phát triển của vi khuẩn, nấm mốc, kéo dài tuổi thọ và duy trì chất lượng sản phẩm. Tuy nhiên, bên cạnh những lợi ích không thể phủ nhận, CMIT cũng được biết đến là một chất gây mẫn cảm da tiềm ẩn. Bài viết này sẽ đi sâu vào định nghĩa, tính chất, ứng dụng đa dạng, và đặc biệt là những thông tin quan trọng về an toàn sức khỏe, quy định pháp lý, giúp bạn đọc có cái nhìn toàn diện và đưa ra lựa chọn thông thái khi sử dụng các sản phẩm chứa CMIT.
CMIT là gì? Định nghĩa và Vai trò then chốt trong Bảo quản
Bạn có bao giờ thắc mắc tại sao các sản phẩm dạng lỏng như dầu gội, sữa tắm, hay thậm chí là sơn và keo dán lại có thể để được lâu mà không bị biến chất hay bốc mùi khó chịu? Bí mật nằm ở việc sử dụng các chất bảo quản, và Methylchloroisothiazolinone (CMIT) chính là một trong những “người gác cổng” hiệu quả bậc nhất. Về cơ bản, CMIT là một hóa chất tổng hợp thuộc nhóm Isothiazolinone, được thiết kế để tiêu diệt hoặc ngăn chặn sự phát triển của các loại vi sinh vật có hại.
Khái niệm Methylchloroisothiazolinone (CMIT) và tên gọi khác
Methylchloroisothiazolinone là tên gọi hóa học đầy đủ, nhưng trong thực tế, chất này thường được biết đến với các tên gọi và viết tắt thông dụng hơn:
- CMIT (viết tắt phổ biến nhất)
- MCI (viết tắt khác)
- 5-Chloro-2-methyl-4-isothiazolin-3-one (tên hóa học theo danh pháp IUPAC)
CMIT thường được sử dụng dưới dạng dung dịch lỏng, và rất phổ biến khi kết hợp với một chất bảo quản khác cùng nhóm là Methylisothiazolinone (MIT) theo tỷ lệ nhất định, thường là 3:1 (CMIT:MIT). Hỗn hợp này có tên thương mại rất nổi tiếng là Kathon CG. Khi nhìn thấy các tên này trên nhãn thành phần, bạn có thể biết rằng sản phẩm đó đang sử dụng chất bảo quản thuộc nhóm Isothiazolinone.

Vai trò và tầm quan trọng của CMIT trong việc ngăn chặn vi sinh vật
Sự tồn tại của chất bảo quản là cực kỳ cần thiết cho hầu hết các sản phẩm dạng lỏng hoặc chứa nước. Môi trường này là điều kiện lý tưởng cho sự phát triển của nhiều loại vi sinh vật, bao gồm:
- Vi khuẩn: Có thể gây phân hủy sản phẩm, thay đổi màu sắc, mùi và kết cấu.
- Nấm men: Tương tự vi khuẩn, gây biến chất và mùi lạ.
- Nấm mốc: Thường xuất hiện trên bề mặt hoặc trong sản phẩm, gây hỏng hoàn toàn.
Sự phát triển của các vi sinh vật này không chỉ làm giảm chất lượng và hiệu quả của sản phẩm mà còn có thể tạo ra các chất độc hại, gây nguy hiểm cho người sử dụng. CMIT phát huy vai trò bảo quản của mình bằng cách:
- Tiêu diệt hiệu quả phổ rộng các loại vi khuẩn Gram dương, Gram âm, nấm men và nấm mốc.
- Ngăn chặn sự tái nhiễm và phát triển trở lại của chúng trong suốt vòng đời sản phẩm.
Nhờ có CMIT (hoặc các chất bảo quản tương tự), các sản phẩm từ mỹ phẩm, tẩy rửa đến sơn công nghiệp mới có thể được sản xuất hàng loạt, vận chuyển đi xa, lưu trữ trong kho và bày bán trên kệ hàng trong thời gian dài mà vẫn giữ được chất lượng và an toàn khi đến tay người tiêu dùng.
Lịch sử ra đời và phân loại hóa học (Nhóm Isothiazolinone)
Nhóm hóa chất Isothiazolinone được phát triển vào những năm 1970 bởi công ty Rohm and Haas (nay là Dow Chemical) như một giải pháp hiệu quả cho vấn đề kiểm soát vi sinh vật trong các hệ thống công nghiệp. CMIT là một trong những hợp chất đầu tiên và được ứng dụng rộng rãi nhất trong nhóm này, bên cạnh MIT, BIT (Benzisothiazolinone), OIT (Octylisothiazolinone)… Chúng đều có chung cấu trúc vòng Isothiazolinone và cơ chế hoạt động tương tự, nhưng khác nhau ở các nhóm thế gắn vào vòng, dẫn đến sự khác biệt về phổ hoạt động, độ ổn định và mức độ gây mẫn cảm. CMIT, cùng với MIT, là hai thành viên phổ biến nhất trong các sản phẩm tiêu dùng do hiệu quả cao ở nồng độ thấp.
Tính chất hóa học đặc trưng của CMIT
Để hiểu rõ hơn về cách CMIT hoạt động và các yếu tố ảnh hưởng đến hiệu quả của nó, chúng ta cần tìm hiểu về những tính chất hóa học đặc trưng của chất này.
Công thức phân tử, khối lượng phân tử và Số CAS của CMIT
Các thông số nhận dạng hóa học chính của Methylchloroisothiazolinone (CMIT) là:
- Công thức phân tử: C₄H₄ClNOS
- Khối lượng phân tử: 149.59 g/mol
- Số CAS (Chemical Abstracts Service number): 26172-55-4. Đây là mã số duy nhất được gán cho CMIT, rất quan trọng cho mục đích nhận dạng và quy định.
Đặc điểm vật lý (Trạng thái, màu sắc, độ tan)
Ở dạng tinh khiết, CMIT là một chất rắn. Tuy nhiên, nó thường được sản xuất và bán trên thị trường dưới dạng dung dịch lỏng, thường là dung dịch nước với các nồng độ khác nhau (ví dụ: 1.5%, 14%, 24%…).
- Trạng thái: Dung dịch lỏng.
- Màu sắc: Thường không màu đến vàng nhạt hoặc hổ phách.
- Độ tan: Tan tốt trong nước và nhiều dung môi hữu cơ phân cực.
CMIT là một hợp chất tương đối ổn định trong điều kiện pH thấp hoặc trung tính. Tuy nhiên, nó kém bền và dễ bị phân hủy ở môi trường kiềm cao (pH > 8.5), điều này ảnh hưởng đến việc sử dụng nó trong các sản phẩm có tính kiềm mạnh.
Cơ chế hoạt động: CMIT tiêu diệt vi sinh vật như thế nào?
Cơ chế hoạt động của CMIT là phản ứng hóa học. CMIT là một chất oxy hóa nhẹ và hoạt động như một chất kiềm hóa (alkylating agent) đối với các tế bào vi sinh vật. Cụ thể, nó phản ứng mạnh mẽ với các nhóm thiol (-SH) trong các enzyme và protein thiết yếu của vi khuẩn, nấm men và nấm mốc.
Quá trình này diễn ra nhanh chóng và hiệu quả:
- CMIT xâm nhập vào tế bào vi sinh vật: Do kích thước nhỏ và tính tan, CMIT có thể dễ dàng đi qua màng tế bào.
- Phản ứng với nhóm Thiol: Bên trong tế bào, CMIT tìm kiếm và phản ứng với các nhóm thiol tự do (-SH) trên các enzyme quan trọng cho quá trình trao đổi chất, sản xuất năng lượng và tổng hợp vật liệu di truyền.
- Bất hoạt enzyme: Bằng cách liên kết hoặc biến đổi các nhóm thiol, CMIT làm thay đổi cấu trúc và chức năng của các enzyme này, khiến chúng không thể hoạt động được.
- Phá vỡ chức năng tế bào: Sự bất hoạt của nhiều enzyme quan trọng dẫn đến rối loạn nghiêm trọng trong các hoạt động sống của tế bào vi sinh vật.
- Tiêu diệt tế bào: Cuối cùng, sự phá vỡ chức năng tế bào làm cho vi sinh vật không thể tồn tại và chết đi.
Cơ chế này giải thích tại sao CMIT lại có phổ hoạt động rộng và hiệu quả diệt khuẩn/nấm mạnh mẽ ngay cả ở nồng độ rất thấp.

CMIT được ứng dụng ở đâu? Từ Công nghiệp nặng đến Sản phẩm tiêu dùng
Như đã đề cập, CMIT là một chất bảo quản “đa năng” nhờ hiệu quả cao và chi phí hợp lý, do đó nó được ứng dụng trong rất nhiều lĩnh vực khác nhau.
Ứng dụng chính trong ngành mỹ phẩm và chăm sóc cá nhân
Trong ngành mỹ phẩm và chăm sóc cá nhân, CMIT (thường dưới dạng hỗn hợp CMIT/MIT) được sử dụng để ngăn ngừa sự phát triển của vi sinh vật trong sản phẩm, đặc biệt là những sản phẩm chứa nước. Điều này không chỉ giúp bảo quản sản phẩm mà còn đảm bảo an toàn cho người sử dụng, tránh nhiễm khuẩn từ chính sản phẩm họ dùng.
Tuy nhiên, do lo ngại về khả năng gây dị ứng, việc sử dụng CMIT/MIT trong mỹ phẩm đã được quy định rất chặt chẽ bởi các cơ quan quản lý trên thế giới (như Ủy ban Châu Âu, FDA Hoa Kỳ) và tại Việt Nam (Bộ Y tế). Quy định chính là sự phân biệt rõ ràng giữa sản phẩm rửa trôi (wash-off) và không rửa trôi (leave-on).
- Sản phẩm Rửa trôi (Wash-off): Là những sản phẩm được sử dụng trên da hoặc tóc và sau đó được rửa sạch bằng nước trong thời gian ngắn. CMIT/MIT được phép sử dụng trong nhóm này với giới hạn nồng độ tối đa rất thấp để giảm thiểu thời gian tiếp xúc với da. Các sản phẩm phổ biến bao gồm:
- Dầu gội, dầu xả
- Sữa tắm, gel tắm
- Sữa rửa mặt, gel rửa mặt
- Xà phòng nước
- Nước rửa tay
- Kem cạo râu (dạng rửa trôi)
- Sản phẩm Không rửa trôi (Leave-on): Là những sản phẩm lưu lại trên da hoặc tóc trong thời gian dài. Do nguy cơ gây dị ứng cao khi tiếp xúc kéo dài, CMIT/MIT đã bị cấm sử dụng trong các sản phẩm không rửa trôi tại nhiều thị trường, bao gồm Liên minh Châu Âu và Việt Nam. Các sản phẩm này bao gồm:
- Kem dưỡng da (mặt, tay, toàn thân)
- Lotion, sữa dưỡng thể
- Kem chống nắng
- Sản phẩm trang điểm (kem nền, phấn nước…)
- Sản phẩm tạo kiểu tóc (gel, sáp, xịt…)
Việc tuân thủ quy định này là cực kỳ quan trọng để đảm bảo an toàn cho người tiêu dùng.
Vai trò của CMIT trong các sản phẩm tẩy rửa và gia dụng
Trong các sản phẩm tẩy rửa và hóa chất gia dụng, CMIT (thường cũng dưới dạng hỗn hợp CMIT/MIT) là một chất bảo quản hiệu quả và kinh tế. Các sản phẩm này thường chứa nước và các chất hữu cơ, tạo điều kiện thuận lợi cho vi khuẩn và nấm phát triển trong quá trình bảo quản, dẫn đến:
- Giảm hiệu quả tẩy rửa.
- Tạo mùi hôi khó chịu.
- Thay đổi kết cấu sản phẩm.
CMIT giúp ngăn chặn các vấn đề này trong nhiều loại sản phẩm, bao gồm:
- Nước rửa chén
- Nước giặt, bột giặt lỏng
- Nước lau sàn, nước tẩy rửa đa năng
- Nước xả vải
- Chất tẩy rửa bồn cầu
- Các sản phẩm làm sạch dạng lỏng khác.
Nồng độ sử dụng trong các sản phẩm này thường cao hơn so với mỹ phẩm rửa trôi, nhưng vẫn phải tuân thủ các tiêu chuẩn an toàn sản phẩm gia dụng.
Ứng dụng rộng rãi trong công nghiệp
Ngoài các sản phẩm tiêu dùng, CMIT có lịch sử lâu đời và ứng dụng cực kỳ quan trọng trong nhiều quy trình công nghiệp khác nhau. Trong môi trường công nghiệp, nhiễm khuẩn có thể gây ra những thiệt hại đáng kể, từ làm hỏng nguyên liệu, sản phẩm, đến ăn mòn thiết bị và làm tắc nghẽn hệ thống.
Các ứng dụng công nghiệp chính của CMIT bao gồm:
- Xử lý nước công nghiệp: Đặc biệt trong các hệ thống làm mát tuần hoàn, tháp giải nhiệt, hệ thống điều hòa không khí, hệ thống xử lý nước thải. CMIT giúp ngăn chặn sự hình thành màng sinh học (biofilm), kiểm soát vi khuẩn, tảo và nấm gây ăn mòn, tắc nghẽn đường ống và giảm hiệu quả hệ thống.
- Ngành Sơn, Mực in và Keo dán: CMIT là chất bảo quản “trong thùng” (in-can preservation) hiệu quả. Nó được thêm vào các sản phẩm dạng lỏng này để ngăn ngừa sự phát triển của vi khuẩn và nấm trong quá trình lưu trữ trước khi sử dụng, tránh làm hỏng sản phẩm (ví dụ: gây mùi thối, tách lớp, giảm độ nhớt).
- Ngành Giấy và Bột giấy: Kiểm soát vi sinh vật là cần thiết trong quá trình sản xuất giấy để tránh làm hỏng bột giấy, gây đứt giấy, tạo mùi và giảm chất lượng sản phẩm cuối cùng. CMIT là một trong những chất diệt khuẩn được sử dụng cho mục đích này.
- Ngành Dệt nhuộm và Da: CMIT được dùng để bảo quản các dung dịch hồ vải, thuốc nhuộm, hoặc để bảo quản da và các sản phẩm dệt chống lại sự tấn công của vi khuẩn và nấm mốc trong quá trình sản xuất và lưu trữ.
- Công nghiệp Dầu khí: Sử dụng trong các dung dịch khoan, chất lỏng thủy lực để kiểm soát vi khuẩn.
Hiệu quả cao, phổ diệt khuẩn rộng và chi phí tương đối thấp khiến CMIT trở thành lựa chọn kinh tế cho nhiều ứng dụng công nghiệp quy mô lớn.
Hỗn hợp CMIT/MIT (Kathon) và các sản phẩm thương mại phổ biến
Như đã đề cập, CMIT hiếm khi được sử dụng một mình trong các sản phẩm tiêu dùng và một số ứng dụng công nghiệp. Nó thường xuất hiện dưới dạng hỗn hợp với Methylisothiazolinone (MIT). Sự kết hợp này, đặc biệt ở tỷ lệ CMIT:MIT là 3:1 (hay còn gọi là tỷ lệ “chuẩn Kathon”), mang lại một số lợi thế:
- Tác dụng hiệp đồng: Hỗn hợp có thể cho hiệu quả bảo quản tốt hơn so với việc sử dụng riêng lẻ từng chất ở cùng tổng nồng độ.
- Độ ổn định: Hỗn hợp có thể ổn định hơn trong một số điều kiện nhất định.
Tên thương mại Kathon CG (CG viết tắt của Cosmetic Grade) là tên gọi phổ biến nhất cho hỗn hợp CMIT/MIT 3:1 dùng trong ngành mỹ phẩm và chăm sóc cá nhân. Ngoài ra, có nhiều tên thương mại khác của các nhà cung cấp hóa chất trên thế giới cho hỗn hợp này hoặc các dạng CMIT/MIT khác dùng trong công nghiệp.
Việc sử dụng hỗn hợp CMIT/MIT thay vì CMIT đơn lẻ là một thực tế phổ biến trong ngành sản xuất. Do đó, khi tìm hiểu về CMIT, thường không thể tách rời nó khỏi người bạn đồng hành MIT.
Những điều cần biết về an toàn sức khỏe khi sử dụng CMIT
Mặc dù CMIT là một chất bảo quản hiệu quả cao, việc sử dụng nó, đặc biệt là trong các sản phẩm tiếp xúc trực tiếp với con người, cần được xem xét kỹ lưỡng và tuân thủ nghiêm ngặt các quy định về an toàn sức khỏe. Mối quan ngại lớn nhất liên quan đến CMIT là khả năng gây dị ứng.
CMIT: Chất gây dị ứng da tiềm ẩn
CMIT được phân loại là một chất gây mẫn cảm (sensitizer) mạnh. Điều này có nghĩa là khi da tiếp xúc với CMIT, hệ miễn dịch của cơ thể có thể phản ứng, dẫn đến tình trạng mẫn cảm. Sau khi đã bị mẫn cảm, mỗi lần tiếp xúc sau đó (dù với nồng độ rất thấp) đều có thể gây ra phản ứng dị ứng.
Khả năng gây mẫn cảm của CMIT (và hỗn hợp CMIT/MIT) đã được ghi nhận qua nhiều nghiên cứu lâm sàng và báo cáo từ các bác sĩ da liễu trên khắp thế giới. Đây là lý do chính dẫn đến những quy định hạn chế nghiêm ngặt đối với chất này, đặc biệt trong mỹ phẩm.
Viêm da tiếp xúc do CMIT: Biểu hiện và mức độ
Phản ứng dị ứng phổ biến nhất do CMIT gây ra là viêm da tiếp xúc dị ứng (allergic contact dermatitis). Triệu chứng thường không xuất hiện ngay lập tức sau lần tiếp xúc đầu tiên mà có thể phát triển sau nhiều lần tiếp xúc, hoặc thậm chí vài giờ đến vài ngày sau lần tiếp xúc ở người đã bị mẫn cảm trước đó.
Các biểu hiện điển hình của viêm da tiếp xúc dị ứng do CMIT bao gồm:
- Ngứa dữ dội: Đây thường là triệu chứng đầu tiên và khó chịu nhất.
- Đỏ da (ban đỏ): Vùng da tiếp xúc trở nên đỏ ửng.
- Sưng nhẹ: Có thể sưng phù ở vùng da bị ảnh hưởng.
- Nổi mụn nước nhỏ (mụn nước, bọng nước): Đặc trưng của viêm da tiếp xúc cấp tính.
- Khô da, bong tróc, nứt nẻ: Thường xảy ra ở giai đoạn mãn tính hoặc sau khi mụn nước vỡ.
- Da dày lên và sẫm màu: Có thể xuất hiện ở những trường hợp mãn tính, tái phát nhiều lần.
Mức độ phản ứng phụ thuộc vào nồng độ CMIT trong sản phẩm, thời gian tiếp xúc, tần suất tiếp xúc và cơ địa của từng người. Một số người chỉ bị phản ứng nhẹ, trong khi người khác có thể bị viêm da nghiêm trọng, lan rộng và ảnh hưởng đến chất lượng cuộc sống.
Nhóm người có nguy cơ dị ứng cao
Mặc dù bất kỳ ai cũng có thể bị mẫn cảm với CMIT khi tiếp xúc, nhưng một số nhóm người có nguy cơ cao hơn:
- Người có tiền sử viêm da cơ địa (Eczema): Da của họ có hàng rào bảo vệ yếu hơn và hệ miễn dịch da có xu hướng phản ứng mạnh hơn với các tác nhân gây dị ứng.
- Người có làn da nhạy cảm: Những người dễ bị kích ứng hoặc mẩn đỏ với các sản phẩm khác cũng có nguy cơ cao hơn với CMIT.
- Người thường xuyên tiếp xúc với CMIT nồng độ cao: Các công nhân trong các nhà máy sản xuất hóa chất, thợ sơn, thợ làm tóc (do tiếp xúc với thuốc nhuộm, sản phẩm tạo kiểu chứa CMIT/MIT), hoặc những người làm việc trong các ngành công nghiệp sử dụng CMIT/MIT với số lượng lớn.
Cảnh báo và khuyến cáo từ các tổ chức y tế, quản lý
Trước những lo ngại về sức khỏe cộng đồng liên quan đến CMIT và MIT, các tổ chức y tế và cơ quan quản lý trên thế giới đã ban hành nhiều quy định chặt chẽ để hạn chế phơi nhiễm:
- Ủy ban Châu Âu (European Commission): Là một trong những cơ quan đi đầu trong việc thắt chặt quy định. Hiện nay, Ủy ban Châu Âu (theo Phụ lục V của Quy định Mỹ phẩm EU số 1223/2009) chỉ cho phép sử dụng hỗn hợp CMIT/MIT trong các sản phẩm mỹ phẩm rửa trôi với nồng độ tối đa là 0.0015% (15 ppm) dưới dạng hỗn hợp CMIT:MIT 3:1. Việc sử dụng trong các sản phẩm không rửa trôi bị cấm hoàn toàn từ năm 2014.
- Cục Quản lý Thực phẩm và Dược phẩm Hoa Kỳ (FDA): Mặc dù FDA có quy định khác biệt cho từng loại sản phẩm, nhưng nhìn chung, xu hướng là hạn chế sử dụng CMIT/MIT, đặc biệt trong các sản phẩm tiếp xúc lâu trên da.
- Bộ Y tế Việt Nam: Các quy định về quản lý mỹ phẩm tại Việt Nam thường hài hòa với các quy định của ASEAN và Châu Âu. Theo Thông tư số 06/2011/TT-BYT quy định về quản lý mỹ phẩm, CMIT và MIT được liệt kê trong danh mục các chất bảo quản được phép sử dụng trong mỹ phẩm với các điều kiện hạn chế. Cụ thể, hỗn hợp CMIT/MIT (ở tỷ lệ 3:1) chỉ được phép sử dụng trong sản phẩm rửa trôi với nồng độ tối đa 0.0015% (15 ppm). Việc sử dụng trong sản phẩm không rửa trôi là không được phép.
Mục đích của các quy định này là giảm thiểu nguy cơ mẫn cảm cho người tiêu dùng thông qua việc kiểm soát nồng độ và thời gian tiếp xúc.
Cách nhận biết CMIT và các tên gọi liên quan trên nhãn sản phẩm
Để tự bảo vệ mình, đặc biệt nếu bạn có làn da nhạy cảm hoặc tiền sử dị ứng, việc đọc kỹ nhãn thành phần là rất quan trọng. Theo quy định về nhãn mỹ phẩm và sản phẩm tiêu dùng, các thành phần phải được liệt kê theo tên danh pháp quốc tế (INCI name) hoặc tên hóa học phổ biến.
Các tên bạn cần tìm trong danh mục thành phần để nhận biết sự có mặt của CMIT hoặc hỗn hợp CMIT/MIT là:
- Methylchloroisothiazolinone
- Methylisothiazolinone (Nếu chỉ thấy tên này, cần xem xét thêm, vì MIT đơn lẻ vẫn được phép dùng trong sản phẩm không rửa trôi ở nồng độ cao hơn CMIT/MIT hỗn hợp, nhưng MIT đơn lẻ cũng là chất gây mẫn cảm tiềm ẩn và đang bị thắt chặt quy định).
- Methylchloroisothiazolinone/Methylisothiazolinone (tên gọi chung cho hỗn hợp)
- MCI/MI (viết tắt)
- Có thể xuất hiện trong tên thương mại như Kathon CG.
Nếu sản phẩm là dạng không rửa trôi (kem, lotion) và bạn thấy các tên này trong danh sách thành phần, đó là dấu hiệu cho thấy sản phẩm đó có thể không tuân thủ quy định hiện hành hoặc có nguy cơ gây dị ứng cao.
Xử trí khi nghi ngờ bị dị ứng với CMIT
Nếu bạn sử dụng một sản phẩm và nhận thấy các triệu chứng như ngứa, đỏ, sưng, nổi mụn nước hoặc khô da ở vùng da tiếp xúc, đặc biệt là sau khi sử dụng sản phẩm chứa CMIT/MIT, hãy thực hiện các bước sau:
- Ngừng sử dụng sản phẩm ngay lập tức: Đây là bước quan trọng nhất.
- Rửa sạch vùng da bị ảnh hưởng: Dùng nước sạch và xà phòng dịu nhẹ để rửa sạch sản phẩm còn sót lại trên da.
- Chườm lạnh (tùy chọn): Có thể giúp giảm sưng và ngứa.
- Không gãi: Việc gãi có thể làm tổn thương da thêm và tăng nguy cơ nhiễm trùng.
- Tham khảo ý kiến bác sĩ da liễu: Đây là bước cần thiết để được chẩn đoán chính xác và điều trị phù hợp. Bác sĩ có thể thực hiện test áp da (patch test) để xác định bạn có bị dị ứng với CMIT (hoặc các hóa chất khác) hay không.
- Lưu giữ thông tin sản phẩm: Ghi lại tên sản phẩm đã sử dụng, nhãn hàng, và chụp ảnh vùng da bị dị ứng để cung cấp cho bác sĩ.
Việc chẩn đoán và xử trí sớm sẽ giúp kiểm soát tình trạng dị ứng và ngăn ngừa phản ứng nghiêm trọng hơn trong tương lai.
Quy định pháp lý và xu hướng quản lý CMIT
Quản lý hóa chất như CMIT luôn là một thách thức, cân bằng giữa lợi ích công nghiệp và nguy cơ sức khỏe cộng đồng. Các quy định pháp lý đóng vai trò quan trọng trong việc đảm bảo CMIT được sử dụng một cách an toàn và có kiểm soát.
Các tiêu chuẩn và quy định hiện hành về CMIT tại Việt Nam và Quốc tế
Như đã nêu, quy định về CMIT và MIT chủ yếu tập trung vào ngành mỹ phẩm do đây là sản phẩm tiếp xúc trực tiếp và thường xuyên với con người.
- Tại Việt Nam: Theo Thông tư số 06/2011/TT-BYT của Bộ Y tế, hỗn hợp Methylchloroisothiazolinone và Methylisothiazolinone (tỷ lệ 3:1) chỉ được phép sử dụng trong mỹ phẩm rửa trôi với nồng độ tối đa 0,0015%. Cấm sử dụng trong mỹ phẩm không rửa trôi. Các quy định này phù hợp với Hiệp định về Hệ thống hài hòa quản lý mỹ phẩm ASEAN và Quy định của Liên minh Châu Âu.
- Tại Liên minh Châu Âu (EU): Quy định số 1223/2009/EC (đặc biệt là Phụ lục V) quy định chi tiết việc sử dụng chất bảo quản trong mỹ phẩm. Hỗn hợp CMIT/MIT (3:1) chỉ được phép trong sản phẩm rửa trôi với nồng độ tối đa 0,0015% và bị cấm trong sản phẩm không rửa trôi. MIT đơn lẻ từng được phép dùng ở nồng độ cao hơn trong sản phẩm không rửa trôi nhưng sau đó cũng bị cấm trong nhóm này từ năm 2017 do gia tăng báo cáo dị ứng.
- Tại Hoa Kỳ (FDA): FDA không có danh sách cấm hoặc cho phép toàn diện như EU, mà quản lý mỹ phẩm thông qua việc yêu cầu nhà sản xuất đảm bảo an toàn và dán nhãn đúng quy định. Tuy nhiên, các dữ liệu về an toàn, bao gồm khả năng gây mẫn cảm của CMIT/MIT, đều được FDA xem xét.
- Các ứng dụng công nghiệp: Quy định về CMIT trong các ngành công nghiệp khác (xử lý nước, sơn, keo…) thường do các cơ quan quản lý môi trường và công nghiệp chịu trách nhiệm, với các giới hạn nồng độ và yêu cầu xử lý nước thải khác biệt so với mỹ phẩm.
Nhìn chung, các quy định quốc tế và Việt Nam đều hướng tới việc hạn chế phơi nhiễm CMIT/MIT trực tiếp và kéo dài trên da con người, đặc biệt là trong mỹ phẩm không rửa trôi.
Trách nhiệm của nhà sản xuất và yêu cầu về dán nhãn
Để đảm bảo an toàn cho người tiêu dùng và tuân thủ pháp luật, nhà sản xuất có trách nhiệm rất lớn khi sử dụng CMIT/MIT trong sản phẩm của mình:
- Tuân thủ giới hạn nồng độ: Đảm bảo nồng độ CMIT/MIT trong sản phẩm không vượt quá mức tối đa cho phép theo quy định hiện hành của thị trường mà sản phẩm được bán ra.
- Sử dụng đúng loại sản phẩm: Không sử dụng CMIT/MIT trong các sản phẩm không rửa trôi khi đã bị cấm.
- Dán nhãn thành phần rõ ràng: Liệt kê đầy đủ và chính xác thành phần CMIT/MIT trên nhãn sản phẩm theo đúng danh pháp INCI name (ví dụ: Methylchloroisothiazolinone, Methylisothiazolinone, hoặc hỗn hợp).
- Đảm bảo chất lượng nguyên liệu: Sử dụng nguyên liệu CMIT/MIT từ các nhà cung cấp uy tín, đảm bảo độ tinh khiết và nồng độ đúng tiêu chuẩn.
Yêu cầu dán nhãn thành phần là quyền lợi của người tiêu dùng, giúp họ biết được sản phẩm chứa những hóa chất gì và đưa ra quyết định mua sắm phù hợp với nhu cầu và tình trạng sức khỏe của bản thân.
Xu hướng giảm sử dụng CMIT và các giải pháp thay thế
Do lo ngại ngày càng tăng về khả năng gây dị ứng của CMIT và MIT, đặc biệt sau khi các báo cáo về viêm da tiếp xúc tăng lên vào đầu những năm 2010, ngành công nghiệp mỹ phẩm và một số ngành khác đã có xu hướng giảm thiểu hoặc loại bỏ hoàn toàn CMIT/MIT khỏi công thức sản phẩm, đặc biệt là trong các sản phẩm rửa trôi cao cấp hoặc dành cho da nhạy cảm.
Các nhà sản xuất đang tích cực tìm kiếm và sử dụng các chất bảo quản thay thế, bao gồm:
- Phenoxyethanol: Phổ biến, hiệu quả, ít gây mẫn cảm hơn CMIT/MIT nhưng vẫn có những tranh cãi riêng về độ an toàn.
- Các Parabens khác (đã được điều chỉnh quy định): Mặc dù Parabens cũng từng bị “thất sủng”, một số loại Parabens nhất định vẫn được phép sử dụng trong mỹ phẩm ở nồng độ giới hạn và được coi là ít gây dị ứng hơn nhóm Isothiazolinone.
- Benzyl Alcohol, Ethylhexylglycerin: Thường dùng kết hợp với Phenoxyethanol.
- Sodium Benzoate, Potassium Sorbate: Chất bảo quản tự nhiên hơn, hiệu quả ở pH thấp.
- Các Isothiazolinone khác: Ví dụ: Benzisothiazolinone (BIT), Octylisothiazolinone (OIT) – thường dùng trong công nghiệp hoặc các sản phẩm tẩy rửa, có đặc điểm an toàn khác biệt.
- Các hệ bảo quản không chứa chất bảo quản truyền thống: Sử dụng các thành phần có tính năng đa nhiệm (ví dụ: một số chất tạo ẩm, chất hoạt động bề mặt có khả năng kháng khuẩn nhẹ).
Tuy nhiên, việc thay thế CMIT/MIT không phải lúc nào cũng đơn giản. Chất bảo quản thay thế cần phải:
- Có hiệu quả diệt khuẩn/nấm phổ rộng tương đương.
- Ổn định trong công thức sản phẩm (pH, nhiệt độ, tương thích với các thành phần khác).
- Có hồ sơ an toàn chấp nhận được.
- Giá thành hợp lý.
Do đó, CMIT/MIT vẫn tiếp tục được sử dụng rộng rãi, đặc biệt là trong các sản phẩm tẩy rửa và ứng dụng công nghiệp, nơi mối quan tâm về dị ứng da do tiếp xúc rửa trôi là ít hơn và tính kinh tế là yếu tố quan trọng.
Hướng dẫn sử dụng và bảo quản CMIT an toàn
Phần này chủ yếu dành cho các nhà sản xuất, người làm việc trong ngành công nghiệp hóa chất hoặc xử lý nguyên liệu CMIT. Việc sử dụng CMIT/MIT nguyên liệu hoặc dung dịch đậm đặc đòi hỏi sự cẩn trọng cao độ do nồng độ hoạt chất cao hơn rất nhiều so với sản phẩm tiêu dùng cuối cùng.
Liều lượng khuyến cáo và cách pha chế trong sản xuất
Liều lượng CMIT/MIT cần thiết trong một công thức sản phẩm phụ thuộc vào nhiều yếu tố:
- Loại sản phẩm: Mỹ phẩm rửa trôi, tẩy rửa, sơn, keo, nước tuần hoàn…
- Mức độ nhiễm khuẩn tiềm ẩn: Môi trường sản xuất, chất lượng nguyên liệu đầu vào.
- Thành phần công thức: Một số thành phần có thể làm giảm hoặc tăng hiệu quả của CMIT.
- Nồng độ dung dịch CMIT nguyên liệu: Thường là 1.5%, 14%, 24% hoặc cao hơn.
- Quy định pháp lý: Luôn phải tuân thủ giới hạn nồng độ tối đa cho phép cho từng loại sản phẩm.
Nhà sản xuất cần tham khảo hướng dẫn chi tiết từ nhà cung cấp CMIT nguyên liệu và thực hiện các thử nghiệm bảo quản (challenge test) để xác định liều lượng tối ưu, vừa đảm bảo hiệu quả bảo quản, vừa an toàn và tuân thủ quy định. Nồng độ sử dụng điển hình trong mỹ phẩm rửa trôi chỉ khoảng 0.0015% (15 ppm), trong khi trong các ứng dụng công nghiệp có thể cao hơn nhiều, tùy thuộc vào mục đích.
CMIT hoạt động hiệu quả nhất trong khoảng pH nhất định, thường là pH trung tính hoặc hơi acid. Ở pH kiềm cao, CMIT dễ bị phân hủy, làm giảm hiệu quả bảo quản. Do đó, cần lưu ý đến độ pH của công thức khi sử dụng CMIT.
Lưu ý khi bảo quản, vận chuyển và xử lý CMIT
Do CMIT nguyên chất và các dung dịch đậm đặc có khả năng gây ăn mòn và kích ứng mạnh, việc xử lý, bảo quản và vận chuyển cần tuân thủ nghiêm ngặt các quy tắc an toàn hóa chất:
- Đồ bảo hộ cá nhân (PPE): Người tiếp xúc trực tiếp với CMIT đậm đặc phải sử dụng đầy đủ đồ bảo hộ, bao gồm:
- Găng tay chống hóa chất (nitrile, neoprene).
- Kính bảo hộ hoặc tấm che mặt.
- Quần áo bảo hộ chống hóa chất.
- Khẩu trang hoặc mặt nạ phòng độc nếu làm việc trong khu vực có nguy cơ hít phải hơi hoặc bụi.
- Khu vực làm việc: Làm việc trong khu vực thông gió tốt hoặc dưới hút mùi.
- Bảo quản:
- Bảo quản ở nơi khô ráo, thoáng mát.
- Tránh ánh sáng mặt trời trực tiếp và nguồn nhiệt.
- Giữ thùng chứa kín.
- Để xa các chất không tương thích, đặc biệt là các chất oxy hóa mạnh, acid mạnh, kiềm mạnh và các amin.
- Vận chuyển: Tuân thủ các quy định về vận chuyển hàng hóa nguy hiểm nếu nồng độ CMIT cao vượt ngưỡng quy định.
- Xử lý sự cố tràn đổ: Sử dụng vật liệu thấm hút phù hợp (cát, mùn cưa trơ) và thu gom vào thùng chứa an toàn. Rửa sạch khu vực bị ảnh hưởng. Tránh để hóa chất tràn ra môi trường, nguồn nước.
- Xử lý chất thải: Chất thải chứa CMIT phải được xử lý theo quy định về quản lý chất thải nguy hại.
Việc tuân thủ các biện pháp an toàn này giúp bảo vệ sức khỏe người lao động và ngăn ngừa các sự cố môi trường không đáng có.
So sánh CMIT với các chất bảo quản phổ biến khác
Để có cái nhìn khách quan về CMIT, việc so sánh nó với các chất bảo quản khác trên thị trường là cần thiết. Mỗi chất bảo quản đều có ưu nhược điểm riêng, và lựa chọn phù hợp phụ thuộc vào loại sản phẩm, công thức, chi phí, và yêu cầu về an toàn.
Ưu điểm và nhược điểm của CMIT (Hiệu quả, giá thành, an toàn…)
Ưu điểm của CMIT/MIT:
- Hiệu quả cao: Có khả năng diệt khuẩn và nấm phổ rộng rất tốt ngay cả ở nồng độ rất thấp (đặc biệt là hỗn hợp 3:1).
- Tác dụng nhanh: Cơ chế hoạt động phản ứng với nhóm thiol giúp nó tiêu diệt vi sinh vật tương đối nhanh.
- Kinh tế: Đặc biệt trong các ứng dụng công nghiệp quy mô lớn, CMIT/MIT thường có giá thành cạnh tranh hơn so với nhiều chất bảo quản hiệu quả cao khác.
- Độ ổn định tốt ở pH trung tính/acid: Phù hợp với nhiều loại công thức sản phẩm.
Nhược điểm của CMIT/MIT:
- Khả năng gây dị ứng cao: Đây là nhược điểm lớn nhất, dẫn đến việc hạn chế nghiêm ngặt trong mỹ phẩm, đặc biệt là sản phẩm không rửa trôi.
- Kém bền ở pH kiềm cao: Không phù hợp cho các sản phẩm có tính kiềm mạnh.
- Không hiệu quả đối với một số loại vi sinh vật: Như bào tử vi khuẩn (spores).
- Yêu cầu bảo quản và xử lý cẩn thận: Do tính chất ăn mòn và kích ứng ở dạng đậm đặc.
So sánh với Parabens, Phenoxyethanol, Bronopol… (Bảng so sánh)
Dưới đây là bảng so sánh tổng quan CMIT/MIT với một số chất bảo quản phổ biến khác, giúp bạn dễ hình dung hơn về vị trí của nó trong thế giới chất bảo quản.
| Tiêu chí | Hỗn hợp CMIT/MIT (3:1) | Parabens (Methylparaben, Propylparaben…) | Phenoxyethanol | Bronopol | Benzisothiazolinone (BIT) | Sodium Benzoate / Potassium Sorbate |
|---|---|---|---|---|---|---|
| Phổ hoạt động | Rộng (Vi khuẩn, Nấm, Nấm men) | Rộng (Vi khuẩn, Nấm men, Nấm mốc) | Tốt (Vi khuẩn), Kém hơn với Nấm | Rộng (Vi khuẩn), Kém hơn với Nấm | Rộng (Vi khuẩn), Tốt (Nấm) | Tốt (Nấm men, Nấm mốc), Kém (VK) |
| Nồng độ điển hình (Mỹ phẩm rửa trôi) | 0.0015% (15 ppm) | Tối đa 0.4% (đơn), 0.8% (hỗn hợp) | Tối đa 1% | Tối đa 0.1% | Không phổ biến trong mỹ phẩm | Tối đa 0.5% |
| Sử dụng trong mỹ phẩm không rửa trôi | Cấm | Cho phép (trong giới hạn) | Cho phép (tối đa 1%) | Cấm (EU), Hạn chế | Hạn chế/Cấm trong mỹ phẩm | Cho phép (trong giới hạn), cần pH thấp |
| Độ ổn định pH | Tốt ở pH 2-8, kém ở pH > 8.5 | Tốt ở phổ rộng pH | Tốt ở phổ rộng pH | Kém ở pH cao, giải phóng Formaldehyde | Tốt ở phổ rộng pH | Cần pH thấp (<5) |
| Nguy cơ dị ứng/mẫn cảm | Cao (Nhược điểm chính) | Thấp (từng gây tranh cãi nội tiết) | Tương đối thấp (có thể gây kích ứng) | Tương đối thấp (có thể giải phóng Formaldehyde, gây dị ứng) | Tương đối thấp hơn CMIT/MIT | Rất thấp (chủ yếu là kích ứng) |
| Ứng dụng chính | Mỹ phẩm rửa trôi, Tẩy rửa, Công nghiệp | Mỹ phẩm, Dược phẩm | Mỹ phẩm, Dược phẩm | Mỹ phẩm rửa trôi, Tẩy rửa, Công nghiệp | Công nghiệp (sơn, keo), Tẩy rửa | Thực phẩm, Đồ uống, Mỹ phẩm |
(Lưu ý: Bảng này mang tính tổng quát và nồng độ sử dụng có thể thay đổi tùy theo từng loại sản phẩm và quy định cụ thể. Bronopol đã bị cấm hoặc hạn chế nghiêm ngặt trong nhiều sản phẩm do khả năng giải phóng Formaldehyde)
Giải đáp các câu hỏi thường gặp về Methylchloroisothiazolinone (FAQs)
Hiểu rõ CMIT giúp bạn tự tin hơn khi lựa chọn sản phẩm. Dưới đây là một số câu hỏi thường gặp về chất này.
CMIT có an toàn cho mọi loại da không?
Không. CMIT, đặc biệt là hỗn hợp CMIT/MIT, được biết đến là chất gây mẫn cảm da tiềm ẩn. Đối với những người có làn da nhạy cảm, viêm da cơ địa, hoặc đã bị mẫn cảm trước đó, việc tiếp xúc với CMIT dù ở nồng độ rất thấp trong sản phẩm rửa trôi vẫn có thể gây ra phản ứng dị ứng (viêm da tiếp xúc). Tuy nhiên, với nồng độ giới hạn nghiêm ngặt (15 ppm trong sản phẩm rửa trôi) theo quy định của các cơ quan quản lý, nguy cơ này được giảm thiểu đáng kể cho đa số người dùng. CMIT/MIT bị cấm trong sản phẩm không rửa trôi chính vì lý do an toàn cho da khi tiếp xúc kéo dài.
Làm sao để lựa chọn sản phẩm không chứa CMIT?
Để tránh các sản phẩm chứa CMIT hoặc hỗn hợp CMIT/MIT, bạn cần tập thói quen đọc kỹ nhãn thành phần trước khi mua. Tìm kiếm các tên sau trong danh sách thành phần:
- Methylchloroisothiazolinone
- Methylisothiazolinone (nếu đi kèm với Methylchloroisothiazolinone trong danh sách)
- Methylchloroisothiazolinone/Methylisothiazolinone
- MCI/MI
- Kathon CG
Bạn cũng có thể tìm kiếm các sản phẩm được dán nhãn “preservative-free” (không chứa chất bảo quản) hoặc tìm hiểu về các nhãn hàng cam kết không sử dụng nhóm Isothiazolinone. Hãy nhớ rằng sản phẩm “không chứa CMIT” vẫn cần có chất bảo quản khác để đảm bảo an toàn và chất lượng.
CMIT có gây hại cho môi trường không?
Khi được sử dụng và xử lý đúng cách, đặc biệt ở nồng độ thấp trong các sản phẩm tiêu dùng sau khi thải ra hệ thống xử lý nước thải, CMIT có khả năng phân hủy sinh học. Nó cũng không có xu hướng tích lũy sinh học trong chuỗi thức ăn. Tuy nhiên, việc xả trực tiếp CMIT nồng độ cao ra môi trường từ các hoạt động công nghiệp có thể gây hại cho sinh vật thủy sinh. Do đó, các hoạt động công nghiệp sử dụng CMIT cần tuân thủ nghiêm ngặt các quy định về xử lý nước thải. Ở nồng độ sử dụng trong sản phẩm tiêu dùng, tác động môi trường thường được đánh giá là thấp.
CMIT có được phép sử dụng trong thực phẩm không?
Không. CMIT không được phép sử dụng làm chất bảo quản trực tiếp trong thực phẩm hoặc đồ uống cho người. Các quy định về an toàn thực phẩm trên toàn thế giới đều không cho phép CMIT tiếp xúc trực tiếp với thực phẩm ở vai trò chất bảo quản. Tuy nhiên, có thể có một số ứng dụng gián tiếp (ví dụ: trong vật liệu đóng gói) nhưng vẫn phải tuân thủ các tiêu chuẩn an toàn nghiêm ngặt về mức độ thôi nhiễm.
Trẻ em có dùng được sản phẩm chứa CMIT ở nồng độ thấp không?
Theo quy định hiện hành ở Việt Nam và EU, hỗn hợp CMIT/MIT được phép sử dụng trong sản phẩm mỹ phẩm rửa trôi với nồng độ tối đa 0.0015% (15 ppm). Nếu sản phẩm dành cho trẻ em là dạng rửa trôi (như sữa tắm, dầu gội) và tuân thủ đúng nồng độ này, về mặt pháp lý là được phép. Tuy nhiên, da trẻ em thường nhạy cảm hơn da người lớn. Nếu trẻ có tiền sử da nhạy cảm, viêm da cơ địa hoặc dị ứng, cha mẹ nên cân nhắc lựa chọn các sản phẩm chuyên biệt cho da nhạy cảm, có thể sử dụng các hệ bảo quản khác được coi là dịu nhẹ hơn hoặc các sản phẩm được chứng nhận an toàn cho da nhạy cảm. Việc đọc kỹ nhãn và tham khảo ý kiến bác sĩ nhi khoa hoặc da liễu là lời khuyên hữu ích.
CMIT hiện tại: Vai trò, Rủi ro và Khuyến nghị sử dụng thông minh
Nhìn lại, Methylchloroisothiazolinone (CMIT) là một chất hóa học với hai mặt rõ ràng: một mặt là chất bảo quản, chất diệt khuẩn cực kỳ hiệu quả, kinh tế và đóng vai trò không thể thiếu trong việc đảm bảo chất lượng, an toàn của vô số sản phẩm công nghiệp và tiêu dùng. Mặt khác, nó là một chất gây mẫn cảm da tiềm ẩn, đòi hỏi sự quản lý chặt chẽ và những lưu ý về an toàn khi sử dụng.
Các quy định pháp lý đã ra đời nhằm giảm thiểu rủi ro dị ứng cho người tiêu dùng, đặc biệt là việc cấm sử dụng CMIT/MIT trong mỹ phẩm không rửa trôi và giới hạn nồng độ cực thấp trong sản phẩm rửa trôi.
Đối với người tiêu dùng, việc “sử dụng thông minh” các sản phẩm chứa CMIT/MIT nghĩa là:
- Đọc kỹ nhãn sản phẩm: Nhận biết tên gọi của CMIT/MIT trong danh sách thành phần.
- Hiểu rõ loại sản phẩm: Chỉ chấp nhận CMIT/MIT trong sản phẩm rửa trôi (như sữa tắm, dầu gội, nước rửa chén) và nên tránh xa nếu thấy nó trong sản phẩm không rửa trôi (kem dưỡng da, lotion).
- Lắng nghe làn da của mình: Nếu bạn có làn da nhạy cảm hoặc tiền sử dị ứng, hãy cân nhắc lựa chọn các sản phẩm không chứa nhóm Isothiazolinone hoặc được thiết kế riêng cho da nhạy cảm.
- Tham khảo ý kiến chuyên gia: Nếu có bất kỳ lo ngại nào về phản ứng da, hãy hỏi bác sĩ da liễu.
Trong bối cảnh thị trường ngày càng quan tâm đến các sản phẩm “thân thiện” và “ít hóa chất”, xu hướng tìm kiếm các chất bảo quản thay thế an toàn hơn cho CMIT/MIT sẽ tiếp tục phát triển. Tuy nhiên, với vai trò quan trọng trong công nghiệp và các sản phẩm tẩy rửa, CMIT có lẽ vẫn sẽ là một phần của thế giới hóa chất hiện đại trong tương lai gần, miễn là được sử dụng một cách có trách nhiệm và tuân thủ nghiêm ngặt các quy định an toàn.
Kết luận
Việc hiểu rõ về các thành phần hóa học như Methylchloroisothiazolinone (CMIT) giúp bạn trở thành một người tiêu dùng thông thái hơn. Tại NumNim, chúng tôi hiểu rằng sự an toàn và sức khỏe của gia đình, đặc biệt là trẻ nhỏ, là ưu tiên hàng đầu. Chúng tôi luôn nghiên cứu và lựa chọn cẩn thận các thành phần trong sản phẩm nước giặt quần áo trẻ em của mình để đảm bảo hiệu quả làm sạch vượt trội đồng thời an toàn, dịu nhẹ cho làn da nhạy cảm của bé và thân thiện với môi trường. NƯỚC GIẶT QUẦN ÁO TRẺ EM NUMNIM THAILAND – Lựa chọn yêu thương của Mẹ.
Thông tin NumNim
Địa chỉ: Tầng 2, Hà Đô Airport Building, số 2 Hồng Hà, Phường 02, Tân Bình, TP. Hồ Chí Minh, Việt Nam
Hotline: 0979951749
𝐖𝐞𝐛𝐬𝐢𝐭𝐞: www.numnim.com.vn
𝐙𝐚𝐥𝐨 𝐎𝐀: 𝟎𝟗𝟕𝟗.𝟗𝟓𝟏.𝟕𝟒𝟗
Quý NPP, Đại Lý Sỉ Lẻ có nhu cầu trở thành Đối tác vui lòng liên hệ theo số điện thoại: 𝟎𝟗𝟏𝟐.𝟐𝟗𝟗.𝟑𝟎𝟗 – 𝟎𝟗𝟑𝟕.𝟗𝟕𝟑.𝟖𝟑𝟗 (𝐳𝐚𝐥𝐨)